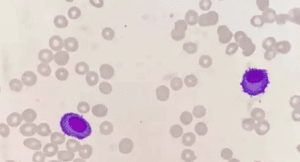

全血细胞减少,该如何思考?
引子
我们检验人讲究的是发散思维,也算是内科医生哦。可有临床医生说,你们检验医师/技师开仪器是一天开始,关仪器是一天结束,检验日子就这么一天天爽过去了。我碰到这样的同事是相当恼火的。如果没有点水平,我们的检验结果能发出去吗?而且,我们仅仅根据血常规及形态就诊断的血液病还是不少滴。就让我举个例子,说下这个故事。
一、 电话铃叮叮急响,医生怕“小三”来临?
(备注: M3个性张扬,狠毒,辣手摧花,我们形态人喜欢戏称M3为小三)
下了夜班,来到血液室小坐会,看着窗外比农夫山泉还甜的雾霾,想深呼吸几口那会,一顿火燎火急的电话铃响了。我顺手一接,电话那头传来了急促的声音:“陈老师,帮忙快看看+5床的病人骨髓。”
我接电话,一般喜欢问临床表现:“请问下这病人什么临床表现?”
对方仍是很急:“这病人,年轻小伙,双下肢瘀斑,全血细胞减少入院。”
我问:“抽骨髓的时候如何?”大家都知道,干抽,或者高凝等都是有不同的意义的。
对方答“刚抽出来就有点凝,有没有可能是M3?”
我一听,是呀,年轻人,出血,高凝骨髓?还真有点小三的样子。
二、血常规+散点图,凝血常规上证据
我打开病人的血常规和散点图,不像M3啊!再打开凝血常规数据看,更不像M3!血常规结果图如下:

有人会问:“别忽悠,根据血常规你就知道不像M3。”
我说:“区区小三,何足挂齿!”
“哎呦,陈老师什么时候会吹牛了?!”
“看来我不讲出点道道来你是不相信我的了。”我伸出手指,指向这个案例的散点图,说道:“请看,散点图单核细胞区域比例不高,且并没有向右侧(即往SS区域倾斜),这极不像小三的散点图特点。而小三的散点图特点有泪滴形、水滴形等等,无论是高白细胞型还是低白细胞型,单核细胞区域均升高,且向右侧倾斜。这样讲,明白不?如果还理解不了,我附上柏世玉老师关于小三的总结图,如下:”

凝血常规结果如下图:

大家知道,M3疾病凶险,常常是由于发生凝血功能障碍,DIC而致死。这个病人的D二聚体、FDP正常,FIB不低,所以,M3也不像。
三、小三妖精已排除,哪些妖魔作怪?
三系减少明显,淋巴细胞比例达到71.4%,散点图及凝血常规综合看不考虑M3。那么,还有哪些疾病呢? 打开病人的信息:男性,28岁,双下肢瘀斑。
好,信息就到这里,结合临床表现及血常规,脑海里先有这些信息:
1、急性白血病,淋巴比例高,急淋?M0/1?这个方向重点看原始细胞。
2、MDS?原始细胞的比例?发育异常的比例?一系或多系?RA?比例?相关的SF3B1突变阳性否?
3、再障?病毒相关检测结果如何,尤其是肝炎相关病毒,人微小病毒?网织红细胞比例及计数减低明显,重型AA?骨髓增生情况如何,三系如何?造血小粒如何?造血细胞(粒、红、巨)与非造血细胞(淋、单、浆、组织细胞等)比例?
4、急性造血停滞?相关的微小病毒B19?巨原红细胞可见否?中晚幼红少见否?其他两系正常否?
5、MF?临床表现,脾大否?外周血形态:幼粒幼红泪滴红三剑客有不?
6、营养相关性三系减低?看叶酸,VB12,MCV,消化道等病史?
7、PNH?看溶血相关检查,CD55/59/FLARE检查?
8、HCL、LGL等相关的淋巴瘤?毛白往往三系减低且单核细胞减低明显,可有脾大否?
9、转移癌?可有肿瘤病史?肿瘤标志物如何?
看看,我们检验人也是有很多的临床思维在里面滴!
二、宏观勾画鉴别点,骨髓形态该如何?
总之不是小三之类致命性疾病,那就慢慢看骨髓吧。深呼吸一口雾霾,夜班的疲惫感烟消云散,顿时精神抖擞看骨髓形态:


一副惟妙惟俏的山水画映入眼底,在我想细看之前,好好的饱餐一番,原来,骨髓形态也是如此的美妙!真是细胞千丝万缕,纤维曼妙舞姿,在眼前把最美好的尽情展示出来,告诉你这疾病的模样!细看呢?

造血岛空心化,纤维化,非造血细胞为主,很符合AA骨髓形态特点。无原始细胞,异常淋巴细胞,巨幼样变细胞等等,排除AL、MDS、MA、HCL、转移癌等等。后经骨髓病理活检确诊为再生障碍性贫血。
后记
通常,我们在自媒体、网络和周围检验人身上都感受到了检验地位低下,价值感不强。甚至,在政策上、学位的改革上,都把检验从医学学位改变为理学学位。可我们毕竟是医院的科室,姓医学而不姓理学,而且,客观上来说,临床很多的疾病诊断、治疗监测、预后等等都离不开我们检验人的工作结果、检验数据。然而,影像、B超,甚至是药学都有临床岗位,而同样为辅助科室的检验科却没有。为什么呢?我想,不仅仅跟政策有关,也跟我们的自身有关。因此,我们在做好自身,提高自身,强壮自身的肌肉上,还需要检验界的领导、主任们去呼吁,去亮出我们检验人的力量,喊出我们检验人的声音。我相信,通过我们检验人不断努力,不仅仅提高了自身的价值地位,也能够很好的作出诊断性报告而更好的服务患者和临床!